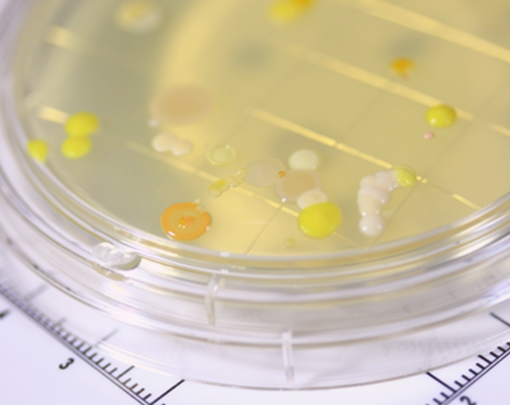

人間を取り巻くさまざまな環境のために。
未知の可能性に挑戦します。
未知の可能性に挑戦します。
株式会社AKI研究所は、山梨県笛吹市を拠点に、環境調査・分析、微生物検査、ISO審査を専門とする企業です。
豊富な知識と技術力を生かして信頼性の高いサービスを提供し、地域の環境保全や品質向上に貢献しています。
豊富な知識と技術力を生かして信頼性の高いサービスを提供し、地域の環境保全や品質向上に貢献しています。
AKI研究所が選ばれる3つの理由
FEATURE

お客様目線の丁寧な対応
分析結果を出すだけでなく、お客様の立場で分かりやすく丁寧にご説明。本当に役立つ情報をご提供します。

どんな依頼にも応える対応力
豊富な経験と強力なネットワークで、多種多様な検査・分析に柔軟対応。他社で断られたご依頼もOKです。

迅速・的確・適正価格
的確な分析を、適正価格で
迅速に提供します。
迅速に提供します。


- 会社概要
COMPANY

株式会社AKI研究所の代表挨拶、会社概要、アクセスについてはこちらからご覧ください。
当社は、人間を取り巻くさまざまな環境の保全と改善に取り組んでおり、未知の可能性に挑戦し、
新たな発見を積み重ねることで、社会に貢献できる企業を目指しています。
当社は、人間を取り巻くさまざまな環境の保全と改善に取り組んでおり、未知の可能性に挑戦し、
新たな発見を積み重ねることで、社会に貢献できる企業を目指しています。
お知らせ
NEWS
ALL
お知らせ
2025.10.31 New お知らせ
ホームページ、リニューアルしました。
ホームページ、リニューアルしました。
様々な情報を発信してまいりますので、どうぞよろしくお願い申し上げます。
2025.10.31 New お知らせ
ホームページ、リニューアルしました。
ホームページ、リニューアルしました。
様々な情報を発信してまいりますので、どうぞよろしくお願い申し上げます。